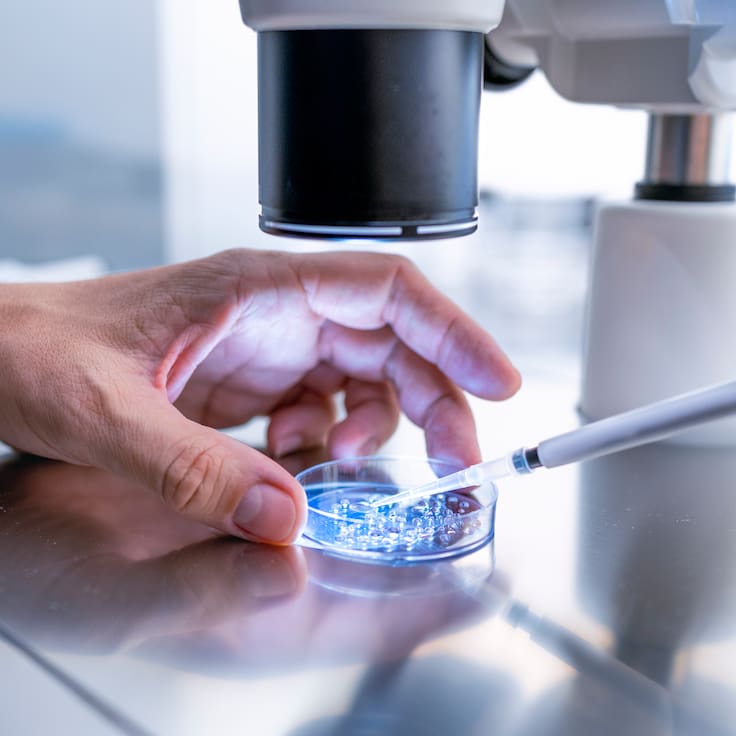
Científicos prueban vacuna universal que promete enfrenta la gripe, COVID y alergias al mismo tiempo

Embajador de EE.UU. tilda de “irrisoria” la sorpresa del Gobierno de Boric ante sanciones por seguridad
Brandon Judd reveló que advirtió personalmente a ministros sobre incursiones extranjeras en sistemas de telefonía que arriesgan la privacidad de los chilenos.